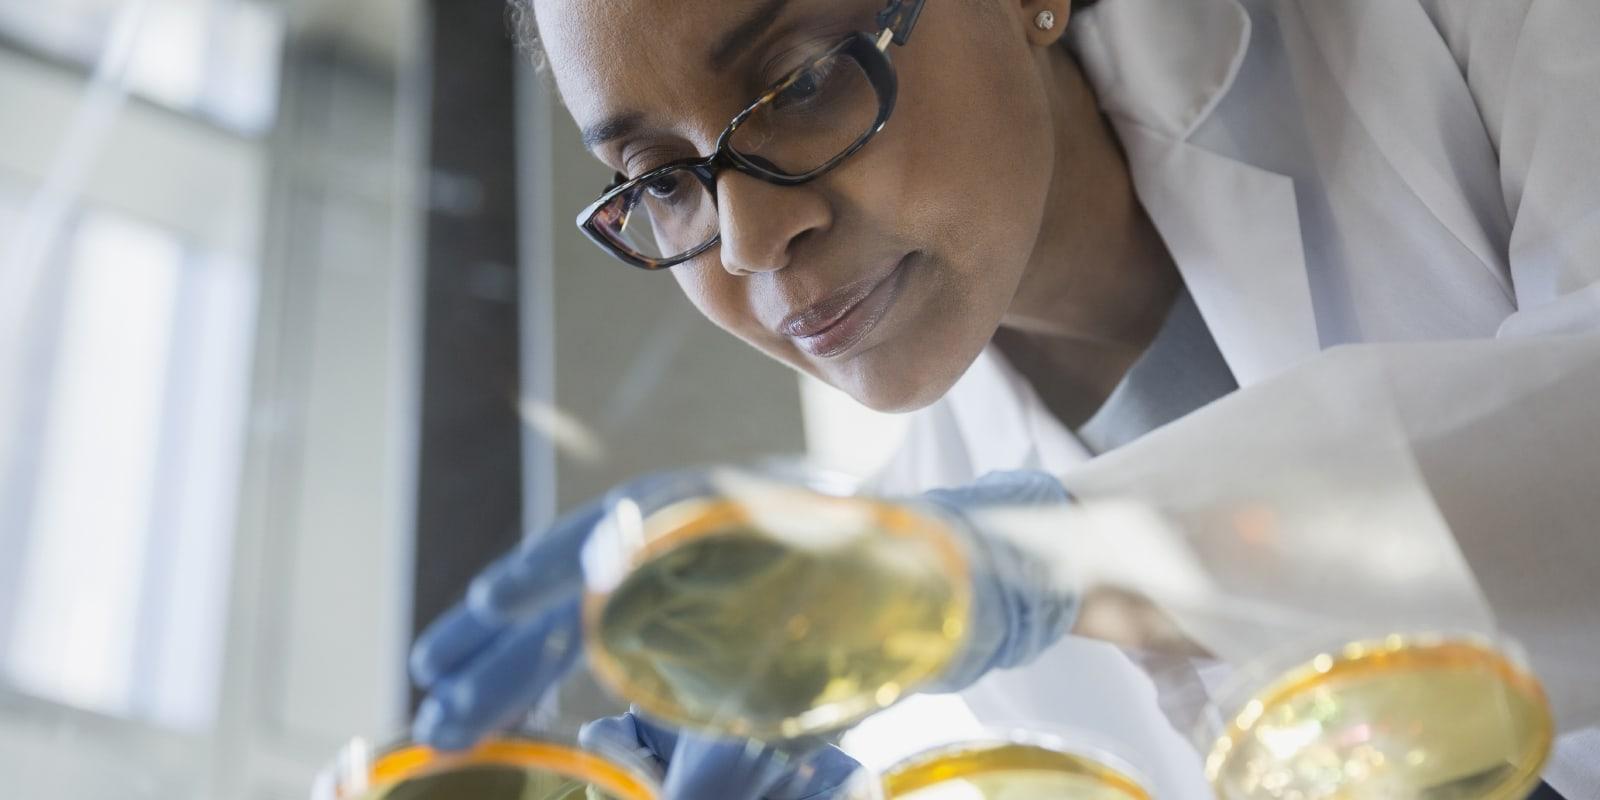

Clinical Trials & Research
Bringing Your Research Goals to Life
Companies engaging in clinical trials are subject to a complex web of regulatory requirements, as well as significant ethical and practical concerns. Any misstep can result in cost escalation and delay with the potential to derail product development. Mintz’s clinical research team partners with clients to help them satisfy this vast set of legal and practical requirements while advancing their programs in a compliant manner.
Share AwardsOur Experience
 Case Study
Case Study
 Case Study
Case Study
 Case Study
Case Study
Our Approach
We provide regulatory, strategic, and practical advice to companies involved with preclinical, clinical, and basic research. We also work with academic medical centers and research staff participating in sponsored clinical research or initiating their own studies. We routinely assist with issues related to study structure and related regulatory and contractual matters, the Institutional Review Board (IRB), Institutional Animal Care and Use (IACUC), biosafety monitoring and related committee review processes. And we advise on issues related to federal grant applications and regulatory compliance, uses and disclosure of health information and personal data for research purposes, and access to and use of tissue and other biological materials for research. We also counsel investors in transactions involving FDA-regulated companies.
- Drafting and review of research consent forms, HIPAA authorizations, recruitment materials, and other participant-facing forms
- Guidance to help ensure successful product development, approval, launch, and marketing efforts
- Preparation for and progress through the Institutional Review Board or Ethics Committee, Institutional Animal Care and Use Committee, Biosafety Monitoring Committee, and Stem Cell Research Oversight Committee review processes
- Risk management advice following adverse events
- Life Sciences Practice
- FDA Practice
- Intellectual Property Practice
- Corporate & Securities Practice
- Litigation Practice
Meet Mintz
Our attorneys collaborate with your team to help you meet regulatory challenges while advancing your business objectives.
Our Insights
Viewpoints

FDA Issues Guidance Addressing COVID-19 Interference with Clinical Trials
March 21, 2020| Blog







